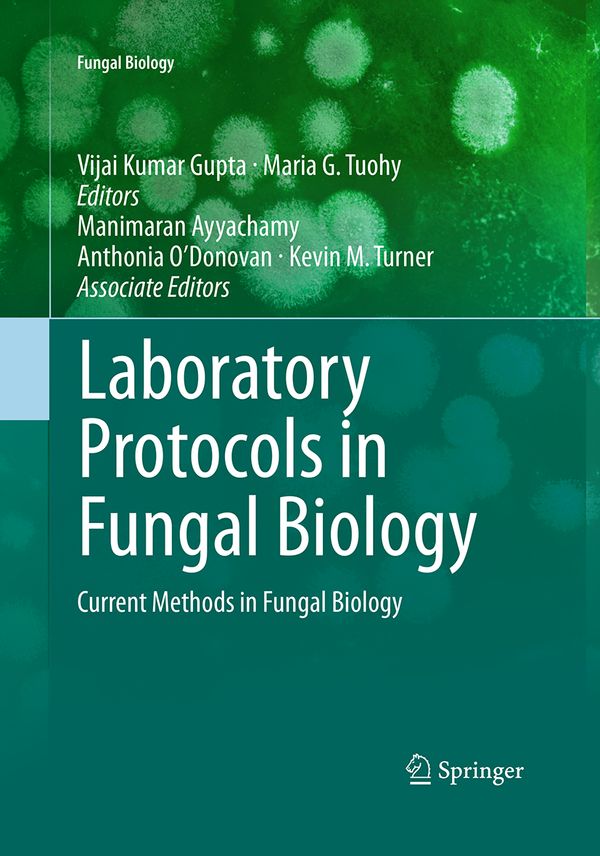
Laboratory Protocols in Fungal Biology | 1:a upplagan

Vi flyttar från butik till nätet - så funkar det framåt
Laboratory Protocols in Fungal Biology | 1:a upplagan
- Häftad, Engelska, 2016
- Författare: Vijai Kumar Gupta, Maria G. Tuohy
- Betyg:
Skickas inom 1-3 vardagar
Vill du sälja den här boken?
Sälj den här bokenBeskrivning
Laboratory Protocols in Fungal Biology presents the latest techniques in fungal biology. This book analyzes information derived through real experiments, and focuses on cutting edge techniques in the field. The book comprises 57 chapters contributed from internationally recognised scientists and researchers. Experts in the field have provided up-to-date protocols covering a range of frequently used methods in fungal biology. Almost all important methods available in the area of fungal biology viz. taxonomic keys in fungi; histopathological and microscopy techniques; proteomics methods; genomics methods; industrial applications and related techniques; and bioinformatics tools in fungi are covered and complied in one book. Chapters include introductions to their respective topics, list of the necessary materials and reagents, step-by-step, readily reproducible laboratory protocols, and notes on troubleshooting. Each chapter is self-contained and written in a style that enables the reader to progress from elementary concepts to advanced research techniques. Laboratory Protocols in Fungal Biology is a valuable tool for both beginner research workers and experienced professionals.
Coming Soon in the Fungal Biology series:
Goyal, Manoharachary / Future Challenges in Crop Protection Against Fungal Pathogens
Martín, García-Estrada, Zeilinger / Biosynthesis and Molecular Genetics of Fungal Secondary Metabolites
Zeilinger, Martín, García-Estrada / Biosynthesis and Molecular Genetics of Fungal Secondary Metabolites, Volume 2
van den Berg, Maruthachalam / Genetic Transformation Systems in Fungi
Schmoll, Dattenbock / Gene Expression Systems in Fungi
Dahms / Advanced Microscopy in Mycology
Om denna bok
Laboratory Protocols in Fungal Biology av Vijai Kumar Gupta och Maria G. Tuohy är en Häftad bok med 604 sidor på Engelska. Detta är den 1:a upplagan som utgavs 2016 av Springer Nature.
Spara pengar – köp begagnad från Campusbokhandeln
Köp Laboratory Protocols in Fungal Biology begagnad från Campusbokhandeln och spara upp till 25% jämfört med nypris. Du kan bevaka den här boken så får du ett mail så fort vi får in den i lager som begagnad.
Genom att köpa & sälja begagnat sänker du kostnaden för studier både för dig och nästa student samtidigt som du gör nytta för klimatet.
Produktinformation